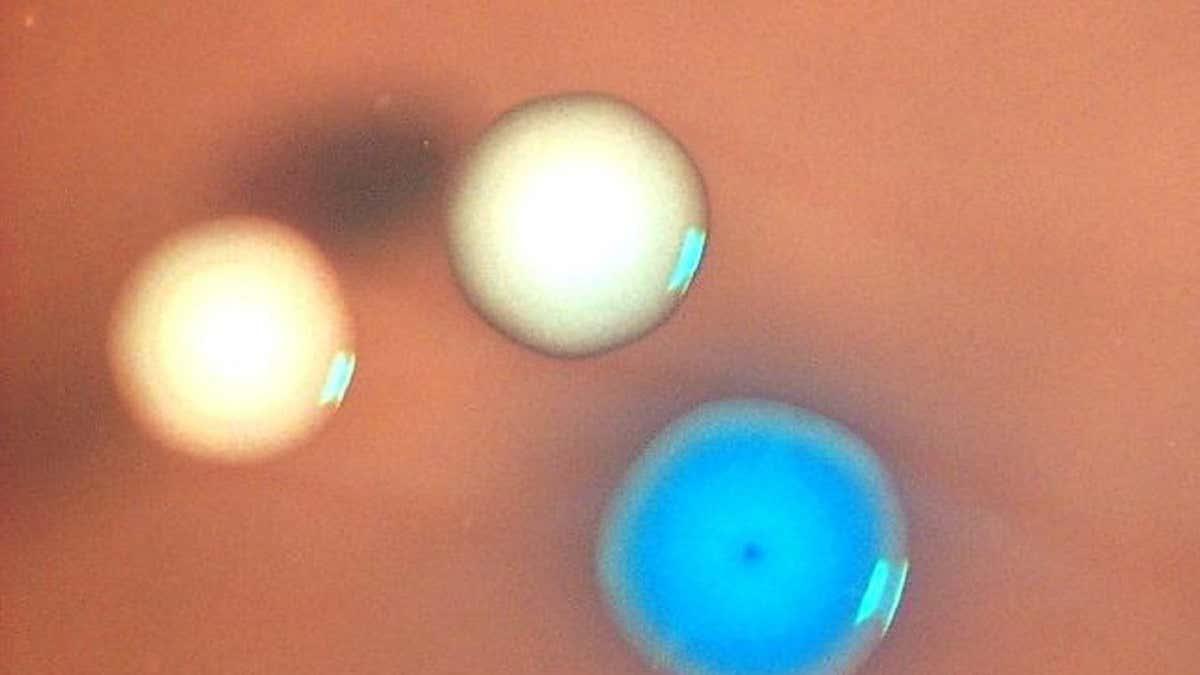

每天更新,最新的趋势和见解,助您提升英语阅读水平。

Meta 和 YouTube 因损害心理健康被罚款300万美元

Meta and YouTube fined $3 million for harming mental health
Meta 和 YouTube 因损害心理健康被罚款300万美元
2026-03-25
446词 简单

本周阅读推荐:引人入胜的《花朵如何改变了我们的世界》

What to read this week: the persuasive How Flowers Made Our World
本周阅读推荐:引人入胜的《花朵如何改变了我们的世界》
2026-03-25
1160词 困难

大脑的清洁系统可以被增强,以去除阿尔茨海默病蛋白质

The brain's cleaning system can be boosted to rid Alzheimer's proteins
大脑的清洁系统可以被增强,以去除阿尔茨海默病蛋白质
2026-03-25
794词 中等

已知最古老的狗扩展了我们犬类伙伴的遗传历史

Oldest known dog extends the genetic history of our canine companions
已知最古老的狗扩展了我们犬类伙伴的遗传历史
2026-03-25
818词 中等

像宇航员一样锻炼如何能减缓背痛和衰老

How working out like an astronaut can reduce back pain and slow ageing
像宇航员一样锻炼如何能减缓背痛和衰老
2026-03-25
2299词 晦涩

为什么克隆并不是真正的克隆——这对克隆意味着什么

Why clones aren't really clones – and what that means for cloning
为什么克隆并不是真正的克隆——这对克隆意味着什么
2026-03-25
847词 中等

具有里程碑意义的实验揭示了克隆技术中的一个重大意外问题

Landmark experiment reveals a big unexpected problem with cloning
具有里程碑意义的实验揭示了克隆技术中的一个重大意外问题
2026-03-25
847词 中等

古代象骨揭示了尼安德特人狩猎的生动细节

Ancient elephant bones reveal vivid details of a Neanderthal hunt
古代象骨揭示了尼安德特人狩猎的生动细节
2026-03-25
1035词 困难

发现气体灶具泄漏致癌化学物质

Cancer-causing chemical found to be leaking from gas cookers
发现气体灶具泄漏致癌化学物质
2026-03-25
646词 中等

地球可能是由围绕太阳的两圈独立环形成的

Earth may have formed from two separate rings around the sun
地球可能是由围绕太阳的两圈独立环形成的
2026-03-24
516词 中等

膀胱炎或牙齿蛀牙可能在几年前就会引发痴呆症

Cystitis or tooth decay could trigger dementia just a few years later
膀胱炎或牙齿蛀牙可能在几年前就会引发痴呆症
2026-03-24
684词 中等

让人震惊的化石显示T. rex并非恐龙之王

The shocking fossils that show T. rex wasn't the king of the dinosaurs
让人震惊的化石显示T. rex并非恐龙之王
2026-03-24
2504词 晦涩

反物质首次通过公路运输

Antimatter has been transported by road for the first time
反物质首次通过公路运输
2026-03-24
435词 简单

人工智能如何震撼全球最大的物理学会议

How AI shook the world's largest meeting of physicists
人工智能如何震撼全球最大的物理学会议
2026-03-24
583词 中等

阿德里安·恰伊科夫斯基:‘我努力创造有趣的外星人’

Adrian Tchaikovsky: 'I try and do interesting aliens'
阿德里安·恰伊科夫斯基:‘我努力创造有趣的外星人’
2026-03-24
2184词 晦涩

人类是否在基因上退化,从而变得愚蠢?

Are humans degenerating genetically and getting dumber as a result?
人类是否在基因上退化,从而变得愚蠢?
2026-03-24
1057词 晦涩

遗传线索揭示了尼安德特人衰退的故事

Genetic clues tell the story of Neanderthals' decline
遗传线索揭示了尼安德特人衰退的故事
2026-03-23
611词 中等

变暖的海洋正在推动南极海冰“状态转变”

Warmer ocean is driving the Antarctic sea ice 'regime shift'
变暖的海洋正在推动南极海冰“状态转变”
2026-03-23
822词 中等

破解意识难题的简单问题

The simple questions cracking the hard problem of consciousness
破解意识难题的简单问题
2026-03-23
2516词 晦涩

神秘彗星解体被望远镜捕捉到,缘于幸运的突破

Mysterious comet disintegration caught by telescope after lucky break
神秘彗星解体被望远镜捕捉到,缘于幸运的突破
2026-03-23
417词 简单

通过将基因组移植到死细菌中创造的“僵尸”细胞
'Zombie' cells created by transplanting genomes into dead bacteria
通过将基因组移植到死细菌中创造的“僵尸”细胞
2026-03-23
816词 晦涩

安全凭证意外泄露于数千个网站上

Security credentials inadvertently leaked on thousands of websites
安全凭证意外泄露于数千个网站上
2026-03-23
580词 中等

你现在可以购买一台DIY量子电脑

You can now buy a DIY quantum computer
你现在可以购买一台DIY量子电脑
2026-03-21
615词 中等

世界首个反物质快递服务内幕

Inside the world’s first antimatter delivery service
世界首个反物质快递服务内幕
2026-03-21
1050词 困难

我们发现了一颗旋转速度极快的巨大小行星

We’ve spotted a huge asteroid spinning impossibly fast
我们发现了一颗旋转速度极快的巨大小行星
2026-03-20
416词 简单

死亡后复活的重要跃进:哺乳动物大脑的保存

Major leap towards reanimation after death as mammal's brain preserved
死亡后复活的重要跃进:哺乳动物大脑的保存
2026-03-20
879词 中等

私营公司将在小行星阿波菲斯靠近地球时进行登陆

Private company to land on asteroid Apophis as it flies close to Earth
私营公司将在小行星阿波菲斯靠近地球时进行登陆
2026-03-20
478词 简单

对衰老持消极态度会让你衰老得更快

A negative attitude towards ageing is making you age faster
对衰老持消极态度会让你衰老得更快
2026-03-20
877词 中等

提高热量产生的益生菌霜可能预防冻伤

Probiotic cream that ramps up heat production could prevent frostbite
提高热量产生的益生菌霜可能预防冻伤
2026-03-19
418词 简单

数学家因解决60年未解之谜而获得2026年阿贝尔奖

Mathematician wins 2026 Abel prize for solving 60-year-old mystery
数学家因解决60年未解之谜而获得2026年阿贝尔奖
2026-03-19
633词 中等